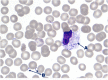

Purpura fulminans
- PMID: 33969348
- PMCID: PMC8087933
- DOI: 10.1002/emp2.12423
Purpura fulminans
Figures
References
-
- Suzuki M, Imaoka K, Haga Y, et al. Characterization of three strains of Capnocytophaga canis isolated from patients with sepsis. Microbiol Immunol. 2018;62(9):567‐573. - PubMed
LinkOut - more resources
Full Text Sources